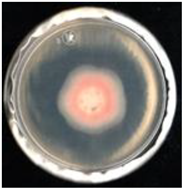
Agronomy 11 01098 i004 Agronomy 11 01098 i004
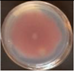
Agronomy 11 01098 i012 Agronomy 11 01098 i012
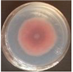
Agronomy 11 01098 i015 Agronomy 11 01098 i015
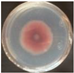
Agronomy 11 01098 i018 Agronomy 11 01098 i018
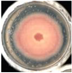
Agronomy 11 01098 i022 Agronomy 11 01098 i022
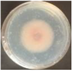
Agronomy 11 01098 i024 Agronomy 11 01098 i024
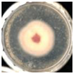
Agronomy 11 01098 i025 Agronomy 11 01098 i025
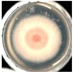
Agronomy 11 01098 i026 Agronomy 11 01098 i026
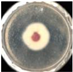
Agronomy 11 01098 i028 Agronomy 11 01098 i028

Abstract
The essential oils of plants of the genus Piper have secondary metabolites that have antimicrobial activity related to their chemical composition. The objective of our work was to determine the chemical composition and evaluate the antifungal activity of the aerial part essential oil of P. auritum obtained by hydrodistillation on Fusarium oxysporum and Fusarium equiseti isolated from Capsicum chinense. The antifungal activity was evaluated by direct contact and poisoned food tests, and the minimum inhibitory concentration (MIC50) and maximum radial growth inhibition (MGI) were determined. The identification of oil metabolites was carried out by direct analysis in real time mass spectrometry (DART-MS). By direct contact, the essential oil reached an inhibition of over 40% on Fusarium spp. The 8.4 mg/mL concentration showed the highest inhibition on F. oxysporum (40–60%) and F. equiseti (>50%). The MIC50 was 6 mg/mL for F. oxysporum FCHA-T7 and 9 mg/mL for F. oxysporum FCHJ-T6 and F. equiseti FCHE-T8. DART-MS chemical analysis of the essential oil showed [2M-H]− and [M-H]− adducts of high relative intensity that were mainly attributed to eugenol and thymol/p-cimen-8-ol. The findings found in this study show a fungistatic effect of the essential oil of P. auritum on Fusarium spp.
1. Introduction
Diseases caused by pathogenic fungi transmitted by the soil constitute an important limitation for the yield and quality of vegetable crops and fruit in intensive agriculture [1]. Chili (Capsicum spp.) is a fruit and spice native to South and Central America [2], which belongs to the Solanaceae family and is known for its flavor and pungency [3]. The genus Capsicum is made up of a group of herbaceous plants [4], of which five species (C. annuum, C. baccatum, C. chinense, C. frutescens and C. pubescens) were domesticated and are currently cultivated in different parts of the world [4,5]. Therefore, from an economic point of view, it is one of the most important vegetables worldwide [4].
Fungal wilt, root rot, and charcoal rot are the most damaging diseases for plant crops, including those of the genus Capsicum [6]. Crown and root rots are by far the most widespread disease caused by Fusarium spp., and several species of Fusarium are recognized as causative agents [7]. Recent reports have reported F. oxysporum as a causative agent of chili root and basal stem rot [8], and most shoot vascular wilt is caused by this species [9]. Fusarium equiseti is a pathogenic species associated with leaf spot, root and crown rot, and fruit rot, which cause seed decomposition and seedling infection in different fruit and vegetable crops, as well as cereals and spices [10].
To combat microbial diseases, chemical control methods are applied that are irritating, toxic, mutagenic, teratogenic, and carcinogenic to users, as well as having serious ecological consequences. Synthetic chemicals provided promising results against wilt; however, fungicide application under field conditions involves environmental contamination, inconsistency in efficacy, and high costs [11]. The development of resistance of pathogenic fungi towards synthetic fungicides is of great concern. Therefore, it is important to develop safe, effective, and friendly fungicides with the environment and with the farmers and producers. This generates interest in alternative (green) sources of antifungal compounds that are more environmentally friendly, and that help reduce the intensive use of these products. Plants have, and continue to be, sources of antifungal compounds [12]. Many of these compounds have biological activity, are more degradable than many pesticides, and can significantly reduce the risk of adverse ecological effects [13]. Plant extracts are an alternative method to the use of chemical substances as a green treatment, since they have a wide variety of secondary metabolites that have demonstrated antimicrobial properties [14]. Essential oils produced by aromatic plants are a complex mixture of volatile secondary metabolites [15] known for their natural components, such as monoterpenes, diterpenes, and hydrocarbons with various functional groups, which have been studied for their antifungal activities [16].
Piper is the largest genus of the Piperaceae family, which is distributed throughout the tropics, with significant concentrations in Central and South America, the Caribbean, Africa, Asia, and some Pacific islands. The aroma emitted by its leaves, fruits and roots has caused the species of this genus to be widely used as a flavoring ingredient in cuisine [17]. It is also used for its therapeutic properties in traditional medicine. The secondary metabolites in extracts from various parts of this plant have shown antifungal, insecticidal, antifeedant, bactericidal and cytotoxic activity [18].
Piper’s secondary compounds such as safrole, dilapiol, myristicin, and methylenedioxyphenyl have been reported to have biological activity [18]. In the analysis of antifungal activity chemical compounds such as safrole and dillapiole obtained from essential oil of P. auritum and P. holtonii, respectively, have been reported to have a direct fungitoxic effect in vitro against Botryodiplodia theobromae and Colletotrichum acutatum, and it was found that the highest values of inhibition of mycelial growth of both fungi were obtained for dillapiole, compared to safrole [19]. There are reports that test different phytoextracts obtained from P. auritum on different phytopathogenic fungi, including the genus Fusarium. The essential oil of P. auritum has been tested against Alternaria solani, inhibiting mycelial growth at seven and fourteen days [20]. In another study, a total inhibition (fungicidal effect) of the mycelial growth of Curvularia lunata, Sarocladium oryzae and Bipolaris oryzae was reported at 96 h [21]. In a previous report, it was observed that the essential oil of P. auritum leaves had an inhibitory effect on the growth of F. oxysporum f. sp. comiteca (75.32%), F. oxysporum f. sp. tequilana (86.57%), and F. solani f. sp. comiteca (63.36%), indicating a fungistatic effect [22]. While in another report, the essential oil of P. auritum caused total inhibition of the growth of F. solani (F2 and F5 isolates) and of F. redolens (F3 isolates) [23].
The increase in food production, the regulations on the use of synthetic fungicides, the development of resistance in phytopathogens justify the search for other control alternatives [6], as the phytochemical that together with an integrated management of the crop could be successful. Therefore, the objective of the present research was to determine the chemical composition and evaluate the antifungal activity of the essential oil of the aerial part of P. auritum on the species of F. oxysporum and F. equiseti causing the wilt in chili.
2. Materials and Methods
2.1. Plant Material and Essential Oil
Leaves and inflorescences (aerial part) of P. auritum were used, which were collected from plants in flowering stage in the municipality of Ocozocoautla de Espinosa, Chiapas in the community of Ocuilapa de Juárez (290° W, between 16°51′16″ N and 93°24′40″ W, 940 mamsl). The leaves and inflorescences were dried at room temperature for 22 days. The dried and ground plant material was stored in conditions of darkness and room temperature until use. The essential oil extraction was carried out by Clevenger hydrodistillation using 20 g of dry plant material and 300 mL of distilled water, for 1 h at 250 °C and at 1000 rpm. Subsequently, the essential oil was separated from the aqueous phase with ethyl ether, the organic phase was collected and evaporated to dryness [24]. The yield in percentage by weight (%, w/w) of the essential oil was calculated with the following equation:
where W1 is the weight of the essential oil after evaporation of the solvent and W2 is the weight of the dry and ground plant material used for extraction [25]. The density and viscosity parameters of the essential oil were determined with an Anton Paar® Stabinger model SVM 3000 digital viscometer.
Yield (%) = (W1 × 100)/W2
2.2. Direct Analysis in Real Time Mass Spectrometry (DART-MS)
For the DART-MS analysis, the essential oil was directly analyzed as a liquid material of organic kind. A capillary tube was immersed in an aliquot of undiluted P. auritum essential oil, then the capillary tube was placed between the helium stream from the DART ionization source and the vacuum interface to obtain mass spectra (MS) [26]. The analysis was carried out on a JMS-T100LP AccuTOF LC-PLUS spectrometer (JEOL, Tokyo, Japan) with a DART SVP100 ion source (Ionsense, Saugus, MA, USA). The DART-MS conditions were in negative mode, the DART ion source was run with helium for analysis and nitrogen for standard mode, the gas temperature (He) was 300 °C, the inlet pressure was 0.55 MPa, and the voltage was ±600 V. The acquisition of the mass spectra was recorded with the Mass Center System Version 1.5.0 k software in a mass range of m/z 50–1000 Da. The analysis was performed between 15 s to 90 s, and the sample was detected at least three times [26].
2.3. Fusarium Strains
The F. oxysporum FCHJ-T6, F. oxysporum FCHA-T7, and F. equiseti FCHE-T8 (GenBank number MG020428, MG020429, MG020433, respectively) strains were provided by Dr. Jairo Cristóbal Alejo and belong to the microbial collection of the Instituto Tecnológico de Conkal. The phytopathogens were isolated from the roots of the habanero pepper (C. chinense). The Fusarium strains were seeded onto 50 mm diameter Petri dishes with potato dextrose agar (PDA) and incubated at 30 ± 2 °C for seven days. On the periphery of the plate, sterile 6 mm diameter Whatman® No. 1 filter paper discs were placed to promote the growth of the phytopathogen on them. Mycelial discs were used as inoculum in all bioassays [27].
2.4. Mycelium Disk Microdiffusion Assay
The antifungal effect by direct contact of the essential oil was determined using the disk microdiffusion method with mycelium [23]. The test was carried out using 50 mm diameter Petri dishes with sterile PDA medium. In each plate, a sterile 6 mm diameter Whatman® No. 1 filter paper disk was deposited on the solidified medium. A volume of 10 µL of essential oil was added to each disc, and then a mycelial disc of Fusarium sp. was placed on them, ensuring direct contact of the mycelium of the fungus with the essential oil. Sterile distilled water was used as a negative control and Sportak® (prochloraz) prepared at a concentration of 1.5 mL/L according to the manufacturer’s instructions as a positive control. The plates were sealed and incubated at 30 ± 2 °C. Three repetitions were used for all the treatments. The mycelial diameter of the fungus was measured with a graduated ruler every 24 h (average of two measurements diametrically opposite) for five days for FCHA-T7 and FCHJ-T6, and six days for FCHE-T8 until the negative control reached the edge of the plate. The evaluation of the percentage of inhibition of radial growth (PIRG) was carried out using the following equation:
where RC is the radius of the mycelium of the negative control and RT is the radius of the mycelium of the treatment [21].
PIRG (%) = [(RC − RT)/RC] × 100
2.5. Poisoned Food Assay
The effect of the essential oil concentration on the antifungal activity on F. oxysporum FCHJ-T6 and FCHA-T7 and F. equiseti FCHE-T8 was determined using the previously reported poisoned food technique [28,29,30]. The essential oil was incorporated into the sterilized and cooled PDA (~50 °C) at the proportions required to reach 0.1 mg/mL, 0.2 mg/mL, 0.4 mg/mL, 3 mg/mL, 5 mg/mL, and 8.4 mg/mL of medium and was poured into sterile 50 mm diameter Petri dishes. Subsequently, a 6 mm diameter mycelial disk of F. oxysporum FCHJ-T6 and FCHA-T7, and F. equiseti FCHE-T8 was placed in the center of the Petri dish with agar. The disk was placed with the mycelium side down [31]. Two types of control and a solvent control were established. The negative control consisted of Petri dishes treated with sterile distilled water (Petri dishes containing PDA without essential oil), the positive control consisted of plates treated with Sportak® (prochloraz) prepared at a concentration of 1.5 mL/L according to the manufacturer’s instructions and the solvent control consisted of Petri dishes containing PDA plus aliquots of ethyl ether used to dissolve the essential oil prior to its incorporation into the sterilized and cooled PDA. The Petri dishes were sealed and incubated in the dark at 30 ± 2 °C. The mycelial diameter was measured every 24 h (average of two measurements diametrically opposite) for six days for FCHA-T7 and FCHJ-T6 and, seven days for FCHE-T8 until the negative control reached the edge of the plate. Three repetitions per treatment were used [31,32,33]. Radial growth inhibition was calculated as a percentage using Equation (2).
2.6. MGI and MIC50 Determination
MGI was defined as the concentration of the essential oil that caused the maximum inhibition of radial growth and MIC50 as the minimum concentration of essential oil that inhibited 50% of the radial growth [34]. The essential oil was added to PDA medium sterilized at 35 °C [32] to reach final concentrations of 5.0 mg/mL, 6.0, 7.0 mg/mL, 8.0 mg/mL, and 9.0 mg/mL. The inoculation was carried out by placing a 6 mm diameter mycelial disk of each fungus in the center of the plate. The negative control contained only PDA. Incubation conditions were in the dark at a temperature of 30 ± 2 °C [31]. All treatments were carried out in triplicate [35]. Measurement of mycelial growth was performed to determine the MGI and MIC50. The radial growth inhibition percentages were calculated using Equation (2).
2.7. Statistical Analysis
Statistical analysis was carried out using a completely randomized design of experiments and the data obtained were analyzed with one-way ANOVA and Tukey’s test at 95% reliability using the STATGRAPHICS Centurion XV.II software, StatPoint Technologies Inc., The Plains, VA, USA.
3. Results
3.1. Aerial Part Essential Oil of P. auritum
Extraction of the essential oil by hydrodistillation using a Clevenger apparatus showed a yield of 2.20% (w/w, dry basis) (Figure 1). The aerial part essential oil extracted consisted of a translucent yellow liquid, oily to the touch, with a light consistency and a strong characteristic odor (Table 1). In the Piper genus, a yield of 3.0% (w/w, dry basis) has been reported for the aerial part essential oil of P. divaricatum obtained by this same technique [36], and 1.58% (w/w, dry basis) for the oil essential from P. auritum leaves [37]. Thus, the yield obtained from leaves and inflorescences of P. auritum is within the previously reported values.

Figure 1.
Extraction of essential oil from aerial part of Pipper auritum through hydrodistillation using a Clevenger apparatus.

Table 1.
Extraction of aerial part essential oil of P. auritum.
3.2. Mass Spectrometry by Direct Analysis in Real-Time (DART-MS)
The chemical profile derived from DART-MS for the aerial part essential oil of P. auritum is presented in Figure 2. Several molecular ions were observed, the most abundant being 149.0308 and 163.0181 m/z. Based on previous reports, it was possible to make assignments for several of these observed m/z ions of the metabolites present in extracts of P. auritum. The ions 149.0308, 163.0181, and 193.0237 m/z corresponded to [M-H]− and [M-H+O2]− adducts of compounds with formula C10H14O, C10H12O2 and C10H10O2, which is consistent with the possible presence of thymol, eugenol and safrole, respectively (Table 2). Table 3 shows the metabolites with molecular formula M that are assigned to the adducts found in the DART mass spectrum. Most of the m/z molecular ions (adducts) were attributed to compounds of a terpenic (cymene and thymol/p-cyme-8-ol) and phenylpropanoid kind (safrole and eugenol), although compounds belonging to the alcohol group (Z3, Z6, E8-dodecatrien-1-ol), aldehyde (2-hexenal), ketone (4-hydroxy-4-methyl-2-pentanone), ester (methyl 2,4-decadienoate), fatty acid (hexadecanoic acid), and alkane (tetradecane) were also detected.

Figure 2.
DART mass spectra of essential oil of P. auritum with a heated argon gas temperature of 300 °C in negative ion mode. The major molecular ions m/z are represented as adducts [M-H]−, [M-H+O2]−, or [2M-H]−. (a) Intensity vs. m/z. (b) Relative intensity vs. m/z. The mass to charge ratio (m/z) of each anion is represented by the value of the peaks. The letter M in blue indicates the molecular weight of the metabolite.

Table 2.
Main metabolite adducts generated in aerial part essential oil of P. auritum by DART-MS and proposed chemical formulas.

Table 3.
List of observed negative molecule and cluster ions detected in aerial part essential oil of P. auritum analyzed in negative mode by DART-MS.
3.3. Antifungal Activity of Essential Oil
3.3.1. Mycelium Disc Microdiffusion Assay
The mycelium disk microdiffusion test is used to demonstrate the natural antifungal effect of the essential oil by direct contact on the fungal microorganism. The results of the biological activity of the essential oil of P. auritum on F. oxysporum FCHJ-T6 and FCHA-T7, and F. equiseti FCHE-T8 after 120 h and 144 h, respectively, are presented in Table 4. The inhibition percentages were greater than 60% in FCHJ-T6 and FCHA-T7 at five days and less than 50% in FCHE-T8 at six days. The results found in the present study indicate that the antifungal effect of the essential oil on the three phytopathogens was also fungistatic.

Table 4.
Antifungal activity of the aerial part essential oil of P. auritum on F. oxysporum FCHA-T7 and FCHJ-T6 and F. equiseti FCHA-T8. Technique: mycelium disc microdiffusion.
3.3.2. Poisoned Food Assay
The biological activity of the essential oil was tested on the three phytopathogens using PDA added with essential oil at six different concentrations. The results of F. oxysporum and F. equiseti after 144 h and 168 h, respectively, are shown in Table 5. In general, an increase in mycelial growth inhibition was observed at the highest concentrations. EO-8.4 showed the greatest inhibition on the three isolates, greater than 50% for FCHJ-T6 and FCHE-T8.

Table 5.
Inhibition of radial growth of Fusarium spp. by aerial part essential oil of P. auritum at different concentrations (mg/mL).
The in vitro antifungal activity of essential oils from Piper spp. at different concentrations against fungi have been previously studied, observing in most cases, fungistatic effect by the bioextracts evaluated. The aerial part essential oil of P. divaricatum showed a high antifungal activity against F. solani f. sp. piperis (greater than 90%) after seven days at a concentration of 5 mg/mL [36]. Therefore, the antifungal effect of aerial part essential oil of P. auritum in poisoned food test corroborates the fungistatic effect, and the inhibition percentage was dependent on the concentration used.
3.3.3. MGI and MIC50 Determination
Due to the fungistatic effect of aerial part essential oil of P. auritum on Fusarium spp., the MGI and MIC50 of the aromatic extract were determined. The results are presented in Table 6. For FCHJ-T6 and FCHE-T8, the MGI and MIC50 were found at 9 mg/mL, while FCHA-T7 showed a MIC50 at 6 mg/mL and an MGI at 9 mg/mL (66.7%).

Table 6.
Fungitoxicity of aerial part essential oil of P. auritum on Fusarium spp.
4. Discussion
In general, essential oils account for less than 5% of dry plant material [37] and among them there is a wide diversity of yield and chemical composition [38]. This variation is under the effect of factors such as species and genotype, ecological conditions, growth stage, and extraction methods [39]. In the present study, we obtained a yield of 2.20%, which is within the range reported for this species.
The Piperaceae family is widely used in cuisine and traditional medicine, and one of its best known genera is Piper. The essential oils of plants of this genus have a wide metabolic diversity [36]. There are more than 270 compounds identified in essential oils from Piper species, and more than 80 of these compounds belonged to the mono and sesquiterpene hydrocarbon classes, followed by aldehydes, alcohols, acids, ketones, esters, and phenols. Some species have a simple profile, while others, such as P. auritum, contain very diverse groups of secondary metabolites. Depending on the organ, it is possible to find differences in the chemical composition of the essential oils of fruits, leaves, and aerial parts [40].
The extracts from leaves and inflorescence of P. auritum are essentially a mixture of alkaloids, safrole, amines, butenolides, flavonoids, and terpenes, among other compounds [41], while the essential oil of this same species is composed of more than 40 compounds, some of them mono and sesquiterpenes [37,42]. The biological activity of the essential oils of P. auritum is due to the different types of secondary metabolites present in each genus of the Piperaceae family, among which the lignans, sesquiterpenes, diterpenes, monoterpenes and phenolic compounds stand out [43]. Previously, the essential oil extracted from P. auritum leaves showed a clear fungistatic effect on three phytopathogenic agave fungi, since it had a significant inhibitory effect (96 h) on F. oxysporum f. sp. comiteca (75.32%), F. oxysporum f. sp. tequilana (86.57%), and F. solani f. sp. comiteca (63.36%) [23]
Chemical analysis by DART-MS of aerial part essential oil of P. auritum showed adducts possibly attributed to terpenes (cymene and thymol/p-cymene-8-ol) and phenylpropanoids (safrole and eugenol), the most intense signals in the mass spectrum being those corresponding to thymol and eugenol (Figure 2, Table 2), although compounds belonging to the alcohol group (Z3, Z6, E8-dodecatrien-1-ol), aldehyde (2-hexenal), ketone (4-hydroxy-4-methyl-2-pentanone), ester (methyl 2,4-decadienoate), fatty acid (hexadecanoic acid), and alkane (tetradecane) were also detected (Table 3).
The presence of compounds of a terpenic and phenylpropanoid kind in aerial part essential oil of P. auritum tested in this study could be related to the fungal effect on Fusarium spp. observed in tests by direct contact (Table 4) and poisoned food (Table 5). However, the role played by the other components detected in the mechanism of inhibition of fungal cell growth is not ruled out.
The bioactivity of essential oils has been reported to result from the interaction between structural components, particularly the main components, although the other compounds in the oil may also have a vital function due to a synergistic effect [44,45] and the direct fungitoxic action of these compounds [31]. Research on the antimicrobial effects of monoterpenes suggests that they diffuse into cells and damage the cell membrane [46]. In addition, other substances present in the essential oil could inhibit mycelial growth or spore germination [31]. For its part, safrole is a methylenedioxy-type compound and its toxic properties have been associated with its structure as a derivative of benzene [45]. This type of compound can reduce the mycelial growth of some plant pathogens, acting as phytoanticipins [19].
Compounds of botanical origin that exhibit resistance to attack by phytopathogenic fungi, such as the essential oil of P. auritum, can serve as agrochemicals taking advantage of their antifungal activity [13]. Therefore, essential oils are one of the most promising groups of natural compounds as an alternative for the development of antifungal agents that are harmless to the environment in the management of diseases in the field and postharvest, due to the effect they exhibit on phytopathogenic fungi [38].
The control of phytopathogenic microorganisms using essential oils can be improved by nanomaterials since nanoparticles are considered as another control alternative [47]. Lipid nanoparticles obtained by encapsulating essential oil have proven to be more efficient and are currently being studied for various purposes [47,48]. Based on the percentages of inhibition obtained with the aerial part essential oil of P. auritum, this could be a good candidate to be used together with this new technology.
5. Conclusions
The results in this study show that the aerial part essential oil of P. auritum had a fungistatic effect on the three Fusarium phytopathogenic isolates tested, finding a MIC50 of 9 mg/mL for F. oxysporum (FCHJ-T6) and F. equiseti (FCHE-T8). F. oxysporum (FCHA-T7) was more sensitive to the bioactivity of the oil, with a MIC50 of 6 mg/mL and MGI of 9 mg/mL, with a percentage of mycelial inhibition greater than 60%. On the other hand, the compounds identified by DART-MS presented chemical diversity, pointing out those of a terpenic and phenylpropanoid kind.
Author Contributions
Designed this study, N.R.-L. and C.C.; analyzed the results, N.R.-L., C.C. and E.B.-Q.; DART-MS, analysis and technical support, L.M.R.-A. and E.B.-Q.; statistically analyzed the date, C.C. and J.A.M.-M.; supervision, N.R.-L., E.R.G.-R., G.C.-C., V.M.R.-V. and J.A.M.-M.; wrote the manuscript, N.R.-L. and C.C.; revised and edited the manuscript, N.R.-L., C.C., E.B.-Q. and G.C.-C. All authors have read and agreed to the published version of the manuscript.
Funding
This research received no external funding.
Institutional Review Board Statement
Not applicable.
Informed Consent Statement
Not applicable.
Data Availability Statement
Not applicable.
Acknowledgments
To the Consejo Nacional de Ciencia y Tecnología (CONACyT)-Mexico for the scholarship awarded to César Chacón (support number 715167) and to Jairo Cristóbal Alejo for providing the fungal strains used in this work.
Conflicts of Interest
The authors declare no conflict of interest.
References
- Li, X.; de Boer, W.; Zhang, Y.; Ding, C.; Zhang, T.; Wang, X. Suppression of soil-borne Fusarium pathogens of peanut by intercropping with the medicinal herb Atractylodes lancea. Soil Biol. Biochem. 2018, 116, 120–130. [Google Scholar] [CrossRef]
- Orobiyi, A.; Dansi, A.; Assogba, P.; Loko, L.Y.; Dansi, M.; Vodouhè, R.; Akouègninou, A.; Sanni, A. Chili (Capsicum annuum L.) in southern Benin: Production constraints, varietal diversity, preference criteria and participatory evaluation. Int. Res. J. Agric. Sci. Soil Sci. 2013, 3, 107–120. [Google Scholar]
- Shafique, S.; Shafique, S.; Ahmad, A. Biochemical and molecular screening of varieties of chili plants that are resistant against Fusarium wilt infection. Eur. J. Microbiol. Immunol. 2018, 8, 12–19. [Google Scholar] [CrossRef]
- Ridzuan, R.; Rafii, M.Y.; Ismail, S.I.; Yusoff, M.M.; Miah, G.; Usman, M. Breeding for anthracnose disease resistance in chili: Progress and prospects. Int. J. Mol. Sci. 2018, 19, 3122. [Google Scholar] [CrossRef]
- Van Zonneveld, M.; Ramirez, M.; Williams, D.E.; Petz, M.; Meckelmann, S.; Avila, T.; Bejarano, C.; Ríos, L.; Peña, K.; Jäger, M.; et al. Screening genetic resources of Capsicum peppers in their primary center of diversity in Bolivia and Peru. PLoS ONE 2015, 10, e134663. [Google Scholar] [CrossRef]
- Madbouly, A.K.; Abdelbacki, A.M.M. Biocontrol of certain soilborne diseases and promotion of growth of Capsicum annuum using biofungicides. Pak. J. Bot. 2017, 49, 371–378. [Google Scholar]
- Jaber, L.R.; Alananbeh, K.M. Fungal entomopathogens as endophytes reduce several species of Fusarium causing crown and root rot in sweet pepper (Capsicum annuum L.). Biol. Control 2018, 126, 117–126. [Google Scholar] [CrossRef]
- Velarde-Félix, S.; Garzón-Tiznado, J.A.; Hernández-Verdugo, S.; López-Orona, C.A.; Retes-Manjarrez, J.E. Occurrence of Fusarium oxysporum causing wilt on pepper in Mexico. Can. J. Plant Pathol. 2018, 41, 238–247. [Google Scholar] [CrossRef]
- Rivera-Jiménez, M.N.; Zavaleta-Mancera, H.A.; Rebollar-Alviter, A.; Aguilar-Rincón, V.H.; García-de-los-Santos, G.; Vaquera-Huerta, H.; Silva-Rojas, H.V. Phylogenetics and histology provide insight into damping-off infections of ‘Poblano’ pepper seedlings caused by Fusarium wilt in greenhouses. Mycol Progress 2018, 17, 1237–1249. [Google Scholar] [CrossRef]
- Gilardi, G.; Pintore, I.; Gullino, M.L.; Garibaldi, A. Occurence of Fusarium equiseti as a contaminant of Diplotaxis tenuifolia seeds. J. Plant Pathol. 2017, 99, 245–248. [Google Scholar] [CrossRef]
- Bhat, M.N.; Mesta, R.; Yenjerappa, S.T.; Tatagar, M.H.; Sardana, H.R.; Singh, D.; Vennila, S.; Sabir, N.; Ahmad, M. Biological control of Fusarium wilt of chillies using Trichoderma spp. Indian J. Hort. 2016, 73, 74–77. [Google Scholar] [CrossRef]
- Mdee, L.; Masoko, P.; Eloff, J. The activity of extracts of seven common invasive plant species on fungal phytopathogens. S. Afr. J. Bot. 2009, 75, 375–379. [Google Scholar] [CrossRef]
- Cespedes, C.L.; Alarcon, J.; Aqueveque, P.M.; Lobo, T.; Becerra, J.; Balbontin, C.; Avila, J.G.; Kubo, I.; Seigler, D.S. New environmentally-friendly antimicrobials and biocides from andean and mexican biodiversity. Environ. Res. 2015, 142, 549–562. [Google Scholar] [CrossRef] [PubMed]
- Zakuan, Z.; Mustapa, S.A.; Sukor, R.; Rukayadi, Y. Antifungal activity of Boesenbergia rotunda (temukunci) extract against filamentous spoilage fungi from vegetables. Int. Food Res. J. 2018, 25, 433–438. [Google Scholar]
- Ray, A.; Jena, S.; Dash, B.; Kar, B.; Halder, T.; Chatterjee, T.; Ghosh, B.; Panda, P.C.; Nayak, S.; Mahapatra, N. Chemical diversity, antioxidant and antimicrobial activities of the essential oils from Indian populations of Hedychium coronarium Koen. Ind. Crop. Prod. 2018, 112, 353–362. [Google Scholar] [CrossRef]
- Salem, M.Z.M.; Zidan, Y.E.; Mansour, M.M.A.; El Hadidi, N.M.N.; Abo Elgat, W.A.A. Antifungal activities of two essential oils used in the treatment of three commercial woods deteriorated by five common mold fungi. Int. Biodeterior. Biodegrad. 2016, 106, 88–96. [Google Scholar] [CrossRef]
- Hao, C.Y.; Fan, R.; Qin, X.W.; Hu, L.S.; Tan, L.H.; Xu, F.; Wu, B.D. Characterization of volatile compounds in ten Piper species cultivated in Hainan Island, South China. Int. J. Food Prop. 2018, 21, 633–644. [Google Scholar] [CrossRef]
- Granados-Echegoyen, C.; Pérez-Pacheco, R.; Bautista-Martínez, N.; Alonso-Hernández, N.; Sánchez-García, J.A.; Martinez-Tomas, S.H.; Sánchez-Mendoza, S. Insecticidal effect of botanical extracts on developmental stages of Bactericera cockerelli (Sulc) (Hemiptera: Triozidae). Southwest. Entomol. 2015, 40, 97–110. [Google Scholar] [CrossRef]
- Vizcaíno-Páez, S.; Pineda, R.; García, C.; Gil, J.; Durango, D. Metabolism and antifungal activity of saffrole, dillapiole, and derivatives against Botryodliplodia theobromae and Colletotrichum acutatum. Bol. Latinoam. Caribe Plantas Med. Aromat. 2016, 15, 1–17. [Google Scholar]
- Duarte, Y.; Pino, O.; Infante, D.; Sánchez, Y.; Travieso, M.; Martínez, B. Efecto in vitro de aceites esenciales sobre Alternaria solani Sorauer. Rev. Prot. Veg. 2013, 28, 54–59. [Google Scholar]
- Duarte, Y.; Pino, O.; Martínez, B. Effect of four essential oils on phytopathogenic fungi associated with spotted rains in rice. Rev. Prot. Veg. 2014, 29, 62–65. [Google Scholar]
- Duarte, Y.; Pino, O.; Martínez, B. Efecto de cuatro aceites esenciales sobre Fusarium spp. Rev. Prot. Veg. 2013, 28, 232–235. [Google Scholar]
- Chacón, C.; Miranda-Granados, J.; Ruiz-Lau, N.; Lagunas-Rivera, S.; Ruíz-Valdiviezo, V.M.; Gutiérrez-Miceli, F.A. Antifungal activity of extracts from hierba santa (Piper auritum) and jarilla (Baccharis glutinosa) against Fusarium spp. Agrociencia 2020, 54, 531–538. [Google Scholar] [CrossRef]
- Besten, M.A.; Jasinski, V.C.G.; Costa, A.G.L.C.; Nunes, D.S.; Sens, S.L.; Wisniewski, A., Jr.; Simionatto, E.L.; Riva, D.; Dalmarco, J.B.; Granato, D. Chemical composition similarity between the essential oils isolated from male and female specimens of each five Baccharis species. J. Braz. Chem. Soc. 2012, 23, 1041–1047. [Google Scholar] [CrossRef]
- Nefzi, A.; Abdallah, R.A.B.; Jabnoun-Khiareddine, H.; Ammar, N.; Medimagh-Saïdana, S.; Haouala, R.; Daami-Remadi, M. Management of Fusarium crown and root rot of tomato by Solanum linnaeanum L. extracts. Sci. Hortic. 2018, 238, 204–214. [Google Scholar] [CrossRef]
- Procacci, S.; Bojórquez-Quintal, E.; Platamone, G.; Maccioni, O.; Lo Vecchio, V.; Morreale, V.; Alisi, C.; Balducchi, R.; Bacchetta, L. Opuntia ficus-indica pruning waste recycling: Recovery and characterization of mucilage from cladodes. Nat. Resour. 2021, 12, 91–107. [Google Scholar] [CrossRef]
- Miranda-Granados, J.; Chacón, C.; Ruiz-Lau, N.; Vargas-Díaz, M.E.; Zepeda, L.G.; Alvarez-Gutiérrez, P.; Meza-Gordillo, R.; Lagunas-Rivera, S. Alternative use of extracts of chipilín leaves (Crotalaria longirostrata Hook. & Arn) as antimicrobial. Sustainability 2018, 10, 883. [Google Scholar] [CrossRef]
- Buitimea-Cantúa, G.V.; Rosas-Burgos, E.C.; Cinco-Moroyoqui, F.J.; Burgos-Hernández, A.; Plascencia-Jatomea, M.; Cortez-Rocha, M.O.; Gálvez-Ruiz, J.C. In vitro effect of antifungal fractions from the plants Baccharis glutinosa and Jacquinia macrocarpa on chitin and β-1,3-glucan hydrolysis of maize phytopathogenic fungi and on the fungal Β-1,3-glucanase and chitinase activities. J. Food Saf. 2013, 33, 526–535. [Google Scholar] [CrossRef]
- Frías-Escalante, M.P.; Burgos-Hernández, A.; Plascencia-Jatomea, M.; Aldana-Madrid, M.L.; Cortez-Rocha, M.O. Antifungal, acute toxicity and mutagenicity activity of extracts from Datura stramonium, Jacquinia macrocarpa and Krameria erecta on Fusarium verticillioides. Afr. J. Biotechnol. 2015, 14, 2251–2257. [Google Scholar] [CrossRef]
- Medina-López, C.F.; Plascencia-Jatomea, M.; Cinco-Moroyoqui, F.J.; Yépiz-Gómez, M.S.; Cortez-Rocha, M.O.; Rosas-Burgos, E.C. Potentiation of antifungal effect of a mixture of two antifungal fractions obtained from Baccharis glutinosa and Jacquinia macrocarpa plants. J. Environ. Sci. Health B 2016, 51, 760–768. [Google Scholar] [CrossRef]
- Silva, J.L.; Souza, P.E.; Monteiro, F.P.; Freitas, M.L.O.; Silva Júnior, M.B.; Belan, L.L. Antifungal activity using medicinal plant extracts against pathogens of coffee tree. Rev. Bras. Plantas Med. 2014, 16, 539–544. [Google Scholar] [CrossRef]
- Avila-Sosa, R.; Gastélum-Reynoso, G.; García-Juárez, M.; Meneses-Sánchez, M.C.; Navarro-Cruz, A.R.; Dávila-Márquez, R.M. Evaluation of different mexican plant extracts to control anthracnose. Food Bioprocess Technol. 2011, 4, 655–659. [Google Scholar] [CrossRef]
- Pineda, R.M.; Vizcaíno, S.P.; García, C.M.P.; Gil, J.H.G.; Durango, D.L.R. Chemical composition and antifungal activity of Piper auritum Kunth and Piper holtonii C. DC. against phytopathogenic fungi. Chil. J. Agric. Res. 2012, 72, 507–515. [Google Scholar] [CrossRef]
- Rosas-Burgos, E.C.; Cortez-Rocha, M.O.; Cinco-Moroyoqui, F.J.; Robles-Zepeda, R.E.; López-Cervantes, J.; Sánchez-Machado, D.I.; Lares-Villa, F. Antifungal activity in vitro of Baccharis glutinosa and Ambrosia confertiflora extracts on Aspergillus flavus, Aspergillus parasiticus and Fusarium verticillioides. World. J. Microbiol. Biotechnol. 2009, 25, 2257–2261. [Google Scholar] [CrossRef]
- Li, R.; Yang, J.-j.; Wang, Y.-f.; Sun, Q.; Hu, H.-b. Chemical composition, antioxidant, antimicrobial and anti-inflammatory activities of the stem and leaf essential oils from Piper flaviflorum from Xishuangbanna, SW China. Nat. Prod. Commun. 2014, 9, 1011–1014. [Google Scholar] [CrossRef] [PubMed]
- Da Silva, J.K.R.; Silva, J.R.A.; Nascimento, S.B.; Da Luz, S.F.M.; Meireles, E.N.; Alves, C.N.; Ramos, A.R.; Maia, J.G.S. Antifungal activity and computational study of constituents from Piper divaricatum essential oil against Fusarium infection in black pepper. Molecules 2014, 19, 17926–17942. [Google Scholar] [CrossRef]
- Conde-Hernández, L.A.; Espinosa-Victoria, J.R.; Guerrero-Beltrán, J.A. Supercritical extraction of essential oils of Piper auritum and Porophyllum ruderale. J. Supercrit. Fluid. 2017, 127, 97–102. [Google Scholar] [CrossRef]
- Scalvenzi, L.; Yaguache-Camacho, B.; Cabrera-Martínez, P.; Guerrini, A. In vitro antifungal activity of essential oils of Ocotea quixos (Lam.) Kosterm. and Piper aduncum L. Bioagro 2016, 28, 39–46. [Google Scholar]
- Moghaddam, M.; Mehdizadeh, L.; Najafgholi, H.M.; Pirbalouti, A.G. Chemical composition, antibacterial and antifungal activities of seed essential oil of Ferulago angulata. Int. J. Food Prop. 2018, 21, 173–185. [Google Scholar] [CrossRef]
- Salehi, B.; Zakaria, Z.A.; Gyawali, R.; Ibrahim, S.A.; Rajkovic, J.; Shinwari, Z.K.; Khan, T.; Sharifi-Rad, J.; Ozleyen, A.; Turkdonmez, E.; et al. Piper species: A comprehensive review on their phytochemistry, biological activities and applications. Molecules 2019, 24, 1364. [Google Scholar] [CrossRef]
- Mendoza-García, E.E.; Ortega-Arenas, L.D.; Pérez-Pacheco, R.; Rodríguez-Hernández, C. Repellency, toxicity, and oviposition inhibition of vegetable extracts against greenhouse whitefly Trialeurodes vaporariorum (Westwood) (Hemiptera: Aleyrodidae). Chil. J. Agric. Res. 2014, 74, 41–48. [Google Scholar] [CrossRef]
- Conde-Hernández, L.A.; Guerrero-Beltrán, J.A. Total phenolics and antioxidant activity of Piper auritum and Porophyllum ruderale. Food Chem. 2014, 142, 455–460. [Google Scholar] [CrossRef]
- Rodríguez-Chaves, D.; Bagnarello-Madrigal, V.; Alpizar-Cordero, J.; Calvo-Vargas, A.; Cordero-Villalobos, M.; Chinchilla-Carmona, M.; Valerio-Campos, I.; Sánchez-Porras, R. Anti-Leishmania (Trypanosomatidae) activity of trans-Z-α-bisabolene epoxide and isolation of safrole, in fruits of Piper auritum (Piperaceae). Rev. Biol. Trop. 2018, 66, 826–835. [Google Scholar] [CrossRef]
- Tangarife-Castaño, V.; Correa-Royero, J.B.; Roa-Linares, V.C.; Pino-Benitez, N.; Betancur-Galvis, L.A.; Durán, D.C.; Stashenko, E.E.; Mesa-Arango, A.C. Anti-dermatophyte, anti-Fusarium and cytotoxic activity of essential oils and plant extracts of Piper genus. J. Essent. Oil Res. 2014, 26, 221–227. [Google Scholar] [CrossRef]
- Caballero-Gallardo, K.; Olivero-Verbel, J.; Pino-Benítez, N.; Stashenko, E.E. Chemical composition and bioactivity of Piper auritum and P. multiplinervium essential oils against the red flour beetle, Tribolium castaneum (Herbst). Bol. Latinoam. Caribe Plantas Med. Aromat. 2014, 13, 10–19. [Google Scholar]
- Singh, S.; Kapoor, I.P.S.; Singh, G.; Schuff, C.; De Lampasona, M.P.; Catalan, C.A.N. Chemistry, antioxidant and antimicrobial potentials of white pepper (Piper nigrum L.) essential oil and oleoresins. Proc. Natl. Acad. Sci. India Sect. B Biol. Sci. 2013, 83, 357–366. [Google Scholar] [CrossRef]
- Vieira, R.; Severino, P.; Nalone, L.A.; Souto, S.B.; Silva, A.M.; Lucarini, M.; Durazzo, A.; Santini, A.; Souto, E.B. Sucupira Oil-Loaded Nanostructured Lipid Carriers (NLC): Lipid Screening, Factorial Design, Release Profile, and Cytotoxicity. Molecules 2020, 25, 685. [Google Scholar] [CrossRef]
- Correa-Pacheco, Z.C.; Bautista-Baños, S.; Hernández-López, M.; Marquina-Valle, M.A. Evaluation of nanoformulations on in vitro development of fungal phytopathogens. Rev. Mex. Fitopatol. 2018, 36, 457–467. [Google Scholar] [CrossRef]
Publisher’s Note: MDPI stays neutral with regard to jurisdictional claims in published maps and institutional affiliations. |
© 2021 by the authors. Licensee MDPI, Basel, Switzerland. This article is an open access article distributed under the terms and conditions of the Creative Commons Attribution (CC BY) license (https://creativecommons.org/licenses/by/4.0/).